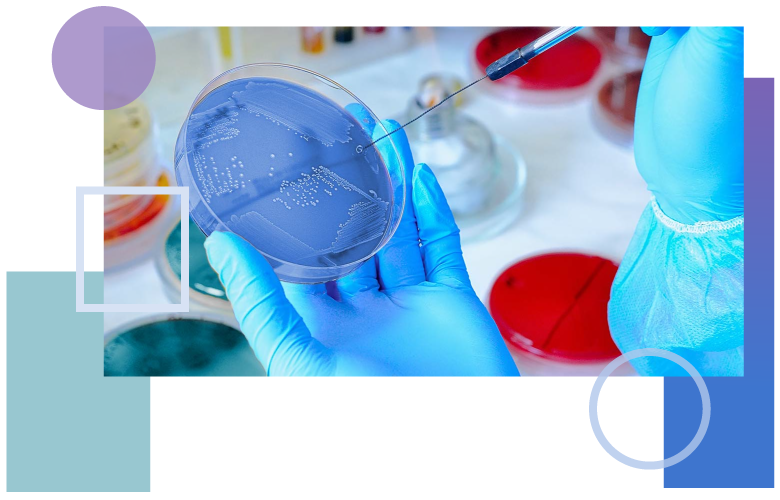

Corporate Research Databases
Our research databases for corporations provide essential resources for professionals working in biotechnology, pharmaceuticals, the medical field, and other industries. Whether you're conducting drug discovery research, developing new therapies, or navigating industry intelligence and trends, these databases offer access to peer-reviewed journals, business magazines, trade publications, and specific insights to support innovation and informed decision-making.